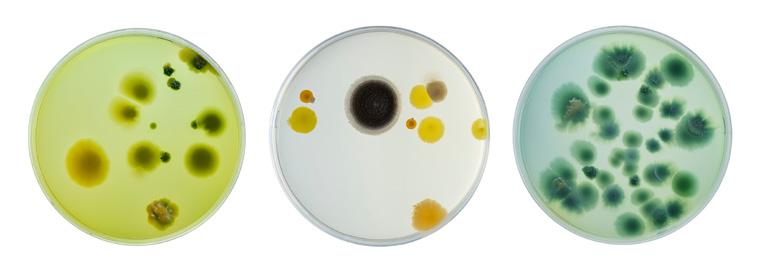

TEST GUIDELINES

![]()

The OECD, which traces its roots to the Marshall Plan, gathers 38 member countries committed to democratic government and the market economy. It provides a forum where governments can compare and exchange policy experiences, identify good practices and adopt decisions and recommendations. Dialogue, consensus and peer review are at the very heart of the OECD.

The OECD is working for a stronger, cleaner and fairer world economy. The principal aim of the Organisation is to promote policies for sustainable economic growth and employment, a rising standard of living, and trade liberalisation. By “sustainable economic growth” the OECD means growth that balances economic, social and environmental considerations.
The OECD is one of the world’s largest and most reliable sources of comparable statistical, economic and social data. It monitors trends, collects data, analyses and forecasts economic development, and investigates evolving patterns in a broad range of public policy areas, such as agriculture, development co-operation, education, employment, environment, taxation and trade, science, technology, industry and innovation.
The OECD family of organisations also includes the International Energy Agency (IEA), the Nuclear Energy Agency (NEA), and the International Transport Forum (ITF).
Mutual Acceptance of Data (MAD) adherents (see page 5)
What OECD Test Guidelines are and how they are used
• They comprise a selection of internationally agreed testing methods applied by governments, industry and Contract Research Organisations (CROs).
• They serve to determine chemical’s physical-chemical properties and environmental fate and behaviour as well as short- and long-term effects on human health and wildlife.
• They are primarily used in regulatory safety testing, e.g. chemical notifications and registrations.
• Their application, and use of resulting data, is specified by chemical regulations in countries considering specific contexts.

The Test Guidelines are an integral part of the OECD Council Decision on the Mutual Acceptance of Data.
OECD is developing Test Guidelines since 1981.
More than 160 harmonised test methods have been developed for determining physical and chemical properties of chemicals, their effects on human health and wildlife, environmental fate and behaviour, and pesticide residue chemistry.
Test Guideline development and update
• Test Guidelines are developed and reviewed with input from experts from governments, regulatory agencies, CROs, academia, validation bodies, industry, other non-governmental and animal welfare organisations. This process is facilitated through national co-ordinators.
• To keep pace with scientific progress and countries’ regulatory needs, Test Guidelines are regularly updated and new ones are developed, such as those recently adopted for nanomaterials and endocrine disruptors.
Over past two decades, OECD has been particularly active in the development of non-animal and other test methods in line with the 3Rs principles on Replacement, Reduction and Refinement of animal-based testing methods.
The 1981 OECD Council Decision on the Mutual Acceptance of Data (MAD) is the cornerstone for the system of standards represented by the OECD Test Guidelines and Good Laboratory Practice (GLP) Principles. This Council Decision requires OECD member and adhering countries to accept test data developed for regulatory purposes in another member or adhering country if these data were developed in accordance with the Test Guidelines and under GLP Principles. The 1989 Council Decision on Compliance with GLP ensures that compliance with the latter is monitored by countries in a harmonised and internationally acceptable manner.

notification or registration of a chemical need to be developed only once by industry and can then be used for regulatory purposes across OECD countries and non-OECD countries which adhere to the system.

Together, these Council Decisions mean that new, nonclinical human health and environmental safety data for
MAD increases the efficiency and effectiveness of chemical notification and registration procedures for both governments and industry. It ensures high-quality test data and a common basis of information for assessing risks to human health and the environment, thereby facilitating government evaluations and project collaboration. MAD also helps limit the number of animals used in testing and animal suffering, and saves time and money for industry by avoiding duplicative testing.
The Council Decision on MAD states that “the data generated in the testing of chemicals in an OECD member or adherent country in accordance with OECD Test Guidelines and OECD Principles of Good Laboratory Practice shall be accepted in other member or adherent countries for purposes of assessment and other uses relating to the protection of humans and the environment.”
Key publication
The Saving Costs in Chemicals Management – How the OECD Ensures benefits to Society report examines the net benefits that accrue to governments and industry from the work of the OECD Environmental, Health and Safety (EHS) Programme. It estimates that the programme saves governments and industry approximately EUR 309 million a year. It also describes the programme’s equally important nonquantifiable benefits.
https://oe.cd/chemicals-costs
The OECD Test Guidelines (TG) for the Testing of Chemicals are split into five sections:
Physical-chemical properties (>25 TG)

Effects on biotic systems (>50 TG)
Environmental fate and behaviour (> 20 TG)
Human health effects (> 80 TG)
Residues chemistry and others (9 TG) SECTION





Proposals for new methods can come from different sources:
• Academic projects oriented towards regulatory applications resulting in proposals for methods standardisation and TG development.
• Innovative companies investing in R&D.
• Government agencies supporting the translation of research findings into regulatory applications.
Projects to develop a TG at the OECD level represent a long-term commitment and require appropriate financial support to complete the various steps of the project.
OECD is exploring ways to make Test Guideline processes more efficient without losing quality and robustness of methods resulting in TG. A Guidance Document on validation, originally published in 2005 is being updated.
Experience and existing resources are shared to benefit developers interested in validating a method for future regulatory application. Read more: https://www.oecd.org/en/topics/sub-issues/testing-of-chemicals/resourcesfor-the-validation-of-testing-methods-for-chemicals2.html
BLUE ARROW: This part of a project ideally would take place before entering the OECD work plan and is the most resource-demanding.
Method optimisation and validation can cost several 100 KEUR.
Validation peer-review Method validation
Method optimisation
Method development
TG development
TG review
TG approval
GREEN ARROW: This part of a project is OECD-specific and typically takes 1.5-3 years Towards regulatory acceptance
There can be limited overlap between the two processes described by the blue and green arrows.
In accordance with the 3Rs principle (Replacement, Reduction, Refinement of animal testing), the Test Guidelines Programme devotes a large portion of its resources towards:
• The development and harmonisation of methods not using animals, but rather, e.g. human or fish cell lines, reconstructed tissues or 3D organoids, as alternatives to whole animal testing.
• Where animal tests are needed: efforts to optimise studies by augmenting utility of information generated for various regulatory contexts to minimise the need for additional animal studies, as well as efforts to include refinement approaches to minimise suffering and distress.
• Facilitating full replacement: develop flexible Integrated Approaches to Testing and Assessment (IATA) or TG based on Defined Approaches (DA) to reduce the number of animals needed for a specific purpose.
Chemical hazards, such as skin and eye irritation/corrosion, serious eye damage and skin sensitisation can now be tested and evaluated using alternative methods for a majority of chemicals on the market, not only cosmetics ingredients.
To keep pace with progress in science and countries’ regulatory needs:
• TG are periodically reviewed, corrected and updated
• New TG are published every year
• New projects are included into the TG Programme work plan every year
Number of projects* on toxicity testing to biotic species (n=19)
Number of projects* for human health methods (n=35)
● Methods on vertebrate species
● Eye irritation
● Methods on non-vertebrate species (plants, insects, worms, cell line...) ●
● Skin sensitisation
● Phototoxicity
● Respiratory sensitisation
● Genotoxicity
* (04/2024)
● Carcinogenicity
Over the past decades, OECD TG have diversified to accommodate different scientific and regulatory challenges and demands. This can be illustrated using in vitro assays as examples, i.e. assays that are based on cells or tissue in culture dishes instead of animal use. While, initially, one TG was developed to assess one hazard, meaning a biological effect, it became clear with time that TG needed to evolve to ensure (i) availability across the globe – leading to Performance-based TG (PB TG), (ii) inclusion of new developments allowing different technologies to target the same biological effect – referred to as Key Event-based TG (KE TG) and, most recently (iii) integration of different (non-animal) information sources to conclude with high confidence on hazard prediction as stand-alone method without the need for expert judgement – being the so-called Defined Approach TG (DA TG).
In 2021, the first DA TG integrating combinations of in vitro, in chemico and in silico methods was adopted by OECD member states and MAD adhering countries for purposes of determining the potential of chemicals to act as skin sensitisers (OECD TG 497).
Test
Guideline
TG
Performancebased (PB) TG
• Include a single test method
• Validated using reference chemicals selected by method developer
• Include >1 validated methods that are technologically and functionally similar
• Measure the same target and use same technology
• Validated using Performance Standards
Key Eventbased (KE) TG
Defined Approach (DA) TG
Examples:
PB TG: TG 455, TG 431
KE TG: TG 442D
DA TG: TG 497
• Include >1 validated methods that are not technologically similar
• Measure the same key event
• Include >1 validated methods that are technologically and functionally diverse
• Methods used in combination to predict the same adverse effect
• Can be in silico/in vitro/in chemico combined with a fixed data interpretation procedure
TG – Validated Reference (VRM) Method 1
Fixed pipeline
Scoring
Performance Standards (PS) based on VRM – Test method components – Reference chemicals – Performance target values Defined algorithm of data handling
Method 2
Method 3
Unequivocal outcome (no expert judgement required) Performance -based (PB) TG
including Methods 1-3 addressing the same KE

Method validation is an essential step towards standardisation and regulatory acceptance
The validation is a demonstration of the relevance and reproducibility of a method. The processes used to achieve validation can be modular and depend on the pre-existing data available for a particular method. An OECD Guidance Document (GD34) is dedicated to validation of Test Methods for hazard assessment and is being updated to reflect on experience gained and future needs for complex in vitro methods.
Generally, method developers should establish:
• a clear scientific basis, and
• for biological methods, relevance, articulated around the mechanisms of action if possible.
The method should be sufficiently described, including:
• test system,
• standard operating procedures,
• reference and control chemicals,
• effects measured,
• data interpretation procedure,
• known technical limitations of the method (i.e. with respect to its applicability),
• data acceptance criteria/quality control measures.
Several templates and examples exist for method description; see, e.g., OECD published guidance on describing non-guideline in vitro methods.
The method should have been demonstrated to be reproducible over time within and between laboratories, using (coded) reference chemicals.
l Chemicals should be representative of the chemicals intended to be tested using the method, and representative of different chemical classes, physical-chemical properties, potencies (strength of the response). The transferability of the method outside the method developer’s laboratory should be done with a sub-set of (coded) chemicals to demonstrate reproducibility between laboratories.
The framework on Adverse Outcome Pathways (AOPs) allows the identification of the cascade of biological events following exposure to a chemical to yield an adverse outcome in humans and in environmental species. AOPs provide the mechanistic underpinning for several in vitro methods that have been developed as OECD Test Guidelines.


Method and test system components should be:
• well characterised
• readily accessible
• available for expert review
• maintained over time in good quality
Test system components, such as cell lines, should be well characterised and their long term availability ensured, e.g., by a cell bank with relevant expertise in the case of cell lines.
Material (cell lines, tissue, reagents, software,…) should be readily accessible. When elements are protected by intellectual property, means to distribute these elements should be in place (e.g. Material Transfer Agreement (MTA), license agreement,…) so as to facilitate the future implementation of the OECD TG at the global level. The OECD developed Guiding Principles on Good Practices for the Availability and Distribution of Protected Elements in OECD Test Guidelines. These principles encourage that, where an MTA or a license agreement needs to be signed between the method provider or intellectual property right holder, such agreement should comply with Fair, Reasonable And Non-Discriminatory (FRAND) terms and conditions.
Method components such as mathematical formulae, algorithm, software, should be available for expert review. Method developer should seek other protection means than secrecy for their assets. While during TG development (prior to TG adoption by OECD countries), protected elements maybe shared within a restricted community, once a TG is published, such information should also be available to the public.
Material composing the method should be maintained in good shape and quality over time. OECD Guidance on Good In Vitro Method Practices should be consulted for further details.


A method is considered ready for Test Guideline development when the test method description and the validation have been satisfactorily established.
The graph below provides only a high level illustration of processes involved with method validation and is described in further detail in Guidance Document 34.
Description of the method
• Scientific basis/biological relevance
• Test system
• Reference and control chemicals
• Standard Operating Procedures (SOP)
• Acceptance criteria/quality control measures
• Data interpretation procedure
• Reproducibility of results over time
STEP 4
The entire method description and supporting information are subject to a peer review
STEP 1
Subject of first check point by the Working Party of National Co-ordinators (WNT)
STEP 2
Assessment of method’s readiness for the transferability to other laboratories
STEP 3
• Transferability of SOPs using reference and control chemicals
• (Coded) Testing of a sub-set of chemicals
• Reproducibility outside the test developer’s laboratory
National Coordinators of the Test Guidelines Programme are government representatives and play a central role. They:
• Submit project proposals to develop Test Guidelines (TG) and other supporting documents such as Guidance Documents (GD) to support the use of TG or Detailed Review Papers for novel areas of testing.
A project proposal is submitted via a Standard Project Submission Form (SPSF).
• Nominate experts for new projects on the work plan and maintain the network of national experts in various areas.
• Serve as focal point for the review of draft documents and consensus building throughout the development process.
• Liaise between OECD and national/regional activities and projects to develop methodologies.
The National Coordinators (NC) ), from the member and adhering countries and the European Union, are organised in a Working Party (WNT) and meet once a year, typically in April. They also hold webinars and workshops on programme-related issues throughout the year.

There are also coordinators for stakeholder groups, such as environmental non-governmental organisations, animal welfare organisations and industry associations who coordinate input into the Test Guidelines Programme.
• What is the regulatory need?
• Is the output for one or more countries?
• Is the proposed TG broadly applicable? (or just for a class of chemicals/a chemical sector)?
• Is the proposed method intended to replace an existing TG?
• What is the validation status of the proposed method?
• What is the action plan and timelines?
• Need for an Expert Group? Meeting needs?
• Are there protected elements? If yes:
– What are they? What type of protection?
– What are the means to ensure broad availability across countries?
• Is the proposed method similar (me-too) to an existing TG?

A vast network of experts who interact during the life of a project

The following areas of expertise are currently very active
• Ecotoxicity testing methods for endocrine disruption
• Individual ecotoxicity testing methods (bees, aquatic plants, etc.)
• Physical-chemical properties on nanomaterials
• Fate and metabolism of nanomaterials
• Skin and respiratory sensitisation
• Eye irritation
• In vitro methods on developmental neurotoxicity
• Genotoxicity testing
• In vitro methods for thyroid disruption
• In vitro immunotoxicity testing
• Development of an IATA for non-genotoxic carcinogens
• Update of the Guidance Document on validation
• Advisory Groups:
– Endocrine Disruption Testing and Assessment
– Emerging Science in Chemicals Assessment
– More groups exist and can become active as projects take off.
DID YOU KNOW?
Altogether, the network involved in Test Guidelines development accounts for more than 1500 experts.

National Coordinator(s) (NC)
Project proposal submission (SPSF)

TG publication
Working Party of NC of the TG Programme (WNT)
Working Party of NC of the TG Programme (WNT) Draft
Decision V Project proposal accepted X Project proposal rejected (?) Project proposal needs further information

Submission for approval
WNT review/comments via written procedure
Lead country(ies) + Expert Group (EG)
Evaluate validation status of the method, any additional info/data needed: Transferability and reproducibility?
Supporting documentation
Consolidation of draft TG within EG
Documents
• Standard Project Submission Form (SPSF)
• TG Programme work plan
• Guidance Documents:
– Validation of New and Updated Methods No. 34 currently under revision
– Good In Vitro Methods Practice No. 298
– Good Practices for the availability/distribution of protected elements in OECD TGs
– Describing Non-Guideline In Vitro Test Methods No. 211
People
• National Coordinators
• OECD Secretariat: ehscont@oecd.org
National Coordinators maintain a vast network of experts. The OECD Secretariat organises the Expert Group by area to provide input into projects aiming at the development of Test Guidelines and guidance documents. Experts come from academia, regulatory agencies, industry, and NGOs (such as animal welfare and citizen organisations).
• OECD Test Guidelines Programme
• Resources for the validation of testing methods for chemicals
• Webinar series on Testing and Assessment Methodologies
• Webinar Series on Emerging Science in Chemicals Assessment
© OECD December 2024
OECD freely authorises the use of this material for non-commercial purposes. All requests for commercial uses of this material or for translation rights should be submitted to rights@oecd.org. All images are from Shutterstock.com.
https://www.oecd.org/en/topics/sub-issues/testing-of-chemicals/test-guidelines.html